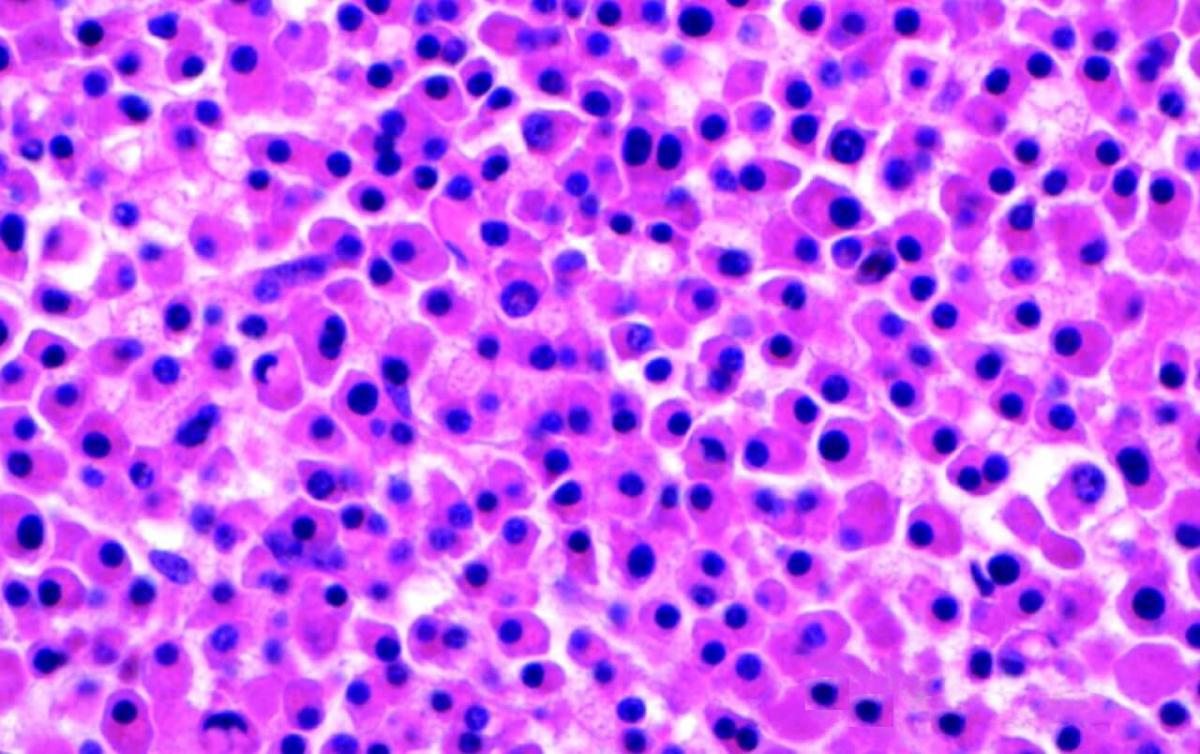
Multipl Miyelom

Multipl Miyelom, bağışıklık sistemi, enfeksiyonlarla ve diğer hastalıklarla savaşmak için birlikte çalışan çeşitli hücre türlerinden oluşur. Lenfositler (lenf hücreleri), bağışıklık sistemindeki ana beyaz kan hücrelerinin tiplerinden biridir ve T hücreleri ve B hücrelerini içerir.Lenfositler, lenf bezleri, kemik iliği, bağırsaklar ve kan akımı gibi vücudun birçok bölgesinde bulunur.B hücreleri bir enfeksiyona cevap verdiğinde olgunlaşır ve plazma hücrelerine dönüşür.Plazma hücreleri, vücudun mikroplara saldırmasına ve öldürülmesine yardımcı olan antikorları (ayrıca immünoglobulinler de denir) yapar.
Plazma hücreleri, özellikle kemik iliğinde bulunur.Kemik iliği, kemiklerin içindeki yumuşak dokudur.Plazma hücrelerine ek olarak, normal kemik iliği ayrıca kırmızı hücreler, beyaz hücreler ve trombositler gibi diğer kan hücrelerininde evidir.Multiple myelom da kontrolsüz çoğalan pazma hücreleri mevcuttur.Plazma hücreleri, monoklonal immünoglobulin, monoklonal protein (M-protein), M-spike veya paraprotein dahil olmak üzere çeşitli adlarla bilinen anormal proteinler (antikor) yapar.
Multipl Miyelom olduğunu nasıl anlarız?
Düşük kan sayımı
Multipl Miyelom, kemik iliğindeki plazma hücrelerinin büyümesi ,normal kan oluşturan hücrelerin çoğalmasına engel olarak düşük kan sayımı oluşturur Bu,kansızlığa(kırmızı kan hücrelerinin yetersizliği) neden olur.Kansızlığı olan insanlar güçsüzleşir ve halsizleşir.Multipl miyelom ayrıca kandaki trombosit seviyesinin düşük olmasına (trombositopenidenir) neden olabilir.Bu artmış kanama ve morarmaya neden olabilir.Gelişebilecek başka bir durum lökopenidir (normal beyaz kan hücrelerinin yetersizliği).Bu enfeksiyonlarla mücadelede sorunlara yol açabilir.Hastalar çeşitli enfeksiyonlara karşı meyilli olur.Kolay hastalanırlar.
Kemik ve kalsiyum problemleri
Miyelom hücreleri ayrıca kemikleri güçlü tutmaya yardımcı olan hücrelere müdahale eder.Kemikler güçlü sürekli yenilenen bir yapıdır.Kemikleri sağlıklı ve güçlü tutmak için iki tür kemik hücresi birlikte çalışır:Osteoklastlar eski kemiği parçalarken,Osteoblastlar yeni kemik oluşumunu sağlar.Miyelom hücreleri, osteoklastlara kemiğin erimesini hızlandırması için bir madde oluşturur.Bu yüzden eski kemik yerine ,yeni oluşturulmuş kemik kullanılmadan parçalanır, bu da kemikleri zayıflatır ve kolay kırılmasını sağlar.Kırılan kemikler, miyelomlu insanlarda büyük bir problemdir.Kemik parçalanmasındaki bu artış, kandaki kalsiyum seviyelerini de artırabilir.Yüksek kalsiyum seviyelerinin neden olduğu problemlerde ayrı bir sorun olur.
Böbrek sorunları
Miyelom hücreleri böbreklere zarar verebilecek, böbrek hasarına ve hatta böbrek yetmezliğine yol açabilecek bir antikor yapar.
Multipl Miyelom Teşhisi
Multiple miyelomu erken yakalamak çoğu zaman daha fazla tedavi seçeneği sunar.Bazı erken kanserlerde farkedilebilen belirti ve semptomlar olabilir, ancak bu her zaman böyle değildir.Multipl miyelomlu bazı hastalarda hiçbir belirti yoktur.Diğerleri de dahil olmak üzere hastalığın ortak belirtileri olabilir.Herhangi bir kemikte olabilen, ancak en sık sırt, kalça ve kafatasındaki kemik ağrısı,Kemik erimesi ya her yerinde (osteoporoz) ya da plazmasitomun olduğu yerde, kemiklerde kırıklar , bazen sadece küçük bir gerilme veya yaralanma yüzünden oluşabilir.Anemi: Zayıflığa, halsizliğe, nefes darlığına ve baş dönmesine neden olan az sayıda kırmızı kan hücresi.
Lökopeni: Zatürree gibi enfeksiyonlara direnci azaltan çok az beyaz kan hücresi.Hiperkalsemi belirtileri:Aşırı susuzluk, çok idrara çıkmak.Böbrek problemleri ve hatta böbrek yetmezliği.Şiddetli kabızlık,karın ağrısı,İştah kaybı.zayıflama,uykuya meyil görülebilir.omurgadaki çökmelere bağlı,fıtıklaşma,bel ağrısı,bacaklarda uyuşma görülebilir.Periferik nöropati yapabilir,bu plasma hücreerinin ürettiği anormal proteinlerin sinirlere toksisitesi yüzünden olur.Çok miktarda proteinin kana karışması ile kanda kıvam artacağından ,kan damarlarında akım yavaşlar,beyine giden akım yavaşladığında baş dönmesi,bilinç bozuklukları.baş dönmesi,bir tafta zayıflık konuşma bozukluğu gibi inme belirtileri,görülebilir.
Nefes darlığı,kaşıntı,bacaklarda şişme gibi,böbrek yetmezliği belirtileri,Miyelomlu bir kişi enfeksiyon kaptığında tedaviye yanıt vermesi yavaş olabilir.Bu kişi uzun süre hasta kalabilir.Zatürree, miyelom hastalarında görülen yaygın ve ciddi bir enfeksiyondur.Bunlara ek olarak kalp problemleri,büyümüş karaciğer,büyümüş dil,ciltte değişilikler,karpal tünel sendromu gibi sinir sıkışmalarıda görülebilir.
Multipl Miyelom Tedavisi
Multiple miyelom tek doktorun tedavi edeceği bir hastalık değildir.Mutlak bir onkoloji,ortopedi,nefroloji,kardiyoloji,hematoloji gibi branşları barındıran tam teşekküllü bir hastanede takibi gerekir.Ortopedik yönden kırıkların tedavisi için yatırılır,veya alçılar uygulanır.Omurgalardaki çökmeler,diğer kemik kırıkları için ameliyatta gerekebilir.diğer sorunlar ,ilgili branşlara havale edilir.